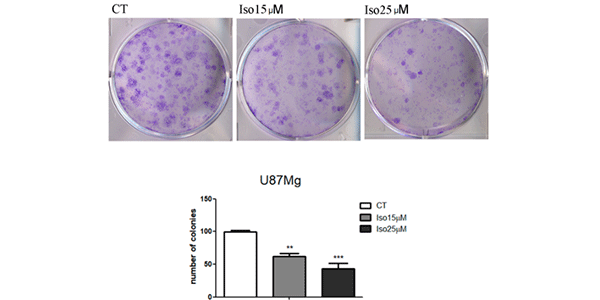

- Anti-infection抗感染
- ADC Related抗体偶联药物相关
- Apoptosis凋亡
- Autophagy自噬
- Cell Cycle/DNA Damage细胞周期/DNA 损伤
- Cytoskeleton细胞骨架
- Epigenetics表观遗传学
- GPCR/G ProteinG 蛋白偶联受体/G 蛋白
- Immunology/Inflammation免疫及炎症
- JAK/STAT SignalingJAK/STAT 信号通路
- MAPK/ERK PathwayMAPK/ERK 信号通路
- Membrane Transporter/Ion Channel跨膜转运
- Metabolic Enzyme/Protease代谢酶/蛋白酶
- Neuronal Signaling神经信号通路
- NF-κBNF-κB 信号通路
- PI3K/Akt/mTORPI3K/Akt/mTOR 信号通路
- PROTAC蛋白降解靶向嵌合体
- Protein Tyrosine Kinase/RTK蛋白酪氨酸激酶
- Stem Cell/Wnt干细胞及 Wnt 通路
- TGF-beta/SmadTGF-beta/Smad 信号通路
- Vitamin D Related/Nuclear Receptor维生素 D 相关/核受体
- Others其他
Anti-infection
Apoptosis
Cell Cycle/DNA Damage
Cytoskeleton
Epigenetics
GPCR/G Protein
- 5-HT Receptor
- Adenylate Cyclase
- Adhesion G Protein-coupled Receptors (AGPCRs)
- Adrenergic Receptor
- Amylin Receptor
- Angiotensin Receptor
- Apelin Receptor (APJ)
- Arf Family GTPase
- Arrestin
- Bombesin Receptor
- Bradykinin Receptor
- Cannabinoid Receptor
- CaSR
- CCR
- CGRP Receptor
- Chemerin Receptor
- Cholecystokinin Receptor
- CRFR
- CXCR
- EBI2/GPR183
Immunology/Inflammation
Membrane Transporter/Ion Channel
Metabolic Enzyme/Protease
- 11β-HSD
- 15-PGDH
- 17β-HSD
- 3β-HSD
- 5 alpha Reductase
- Acetolactate Synthase (ALS)
- Acetyl-CoA Carboxylase
- Acetyl-CoA synthetase
- Acyltransferase
- ADAMTS
- Adiponectin Receptor
- Aldehyde Dehydrogenase (ALDH)
- Aldehyde Oxidase (AO)
- Aldose Reductase
- Amine N-methyltransferase
- Amino Acid Oxidase
- Aminoacyl-tRNA Synthetase
- Aminopeptidase
- Aminotransferases (Transaminases)
- Amylases
Neuronal Signaling
Protein Tyrosine Kinase/RTK
Stem Cell/Wnt
- 重组蛋白
- Cytokines and Growth Factors
- Immune Checkpoint Proteins
- CAR-T related Proteins
- CD Antigens
- Fc Receptors
- Receptor Proteins
- Enzymes & Regulators
- Complement System
- Ubiquitin Related Proteins
- Viral Proteins
- Biotinylated Proteins
- Fluorescent-labeled Proteins
- GMP-grade Proteins
- Animal-free Recombinant Proteins
- 重组蛋白定制
- 定制合成服务
- ADC 相关定制服务
- PROTAC 相关定制服务
- Cytokines and Growth Factors细胞因子和生长因子
- Immune Checkpoint Proteins免疫检查点蛋白
- CAR-T related ProteinsCAR-T 相关蛋白
- CD AntigensCD 抗原
- Fc ReceptorsFc 受体蛋白
- Receptor Proteins受体蛋白
- Enzymes & Regulators酶和调节子
- Complement System补体系统
- Ubiquitin Related Proteins泛素相关蛋白
- Viral Proteins病毒蛋白
- Biotinylated Proteins生物素标记蛋白
- Fluorescent-labeled Proteins荧光标记蛋白
- GMP-grade ProteinsGMP 级蛋白
- Animal-free Recombinant Proteins无动物成分重组蛋白
- Others其他
- View More
CAR-T related Proteins
- CD27 Ligand/CD70
- B Cell Maturation Antigen (BCMA)
- FLK-1/VEGFR-2
- B7-H3
- CD4
- CD19
- CD27 Ligand/CD70
- CD123
- CD138/Syndecan-1
- Epithelial Cell Adhesion Molecule (EpCAM)
- Folate Receptor 1
- GPC-3
- Guanylate Cyclase 2C
- ErbB2/HER2
- ErbB3/HER3
- c-Met/HGFR
- MSLN
- CA-125
- ROR1
- CEACAM-5
- CD314/NKG2D
- Prostate Specific Membrane Antigen
- CD319/SLAMF7
- TROP-2
- Siglec-6
- Folate Receptor alpha (FR-alpha)
- CD314/NKG2D
- Siglec-3/CD33
- CD27 Ligand/CD70
- CD138/Syndecan-1
- CD319/SLAMF7
- ErbB2/HER2
- CD138/Syndecan-1
- Nectin-4
- Siglec-3/CD33
- Carbonic Anhydrase 9 (CA IX)
- EGFR
- FLK-1/VEGFR-2
- CD7
- CD20
- Siglec-2/CD22
- CD30
- CD38
- MUC-1/CD227
CD Antigens
- T Cell CD Proteins
- B Cell CD Proteins
- NK Cell CD Proteins
- Macrophage CD Proteins
- Monocyte CD Proteins
- Stem Cell CD Proteins
- Platelet CD Proteins
- Erythrocyte CD Proteins
- Dendritic Cell CD Proteins
- Epithelial cell CD Proteins
- Endothelial cell CD Proteins
- Signal Transduction-related CD Proteins
- Cell Adhesion-related CD Proteins
Receptor Proteins
- Receptor Tyrosine Kinases
- Receptor Serine/Threonine Kinases
- Receptor Tyrosine Phosphatase
- Receptor Guanylyl Cyclase Family
- Cell Adhesion Molecules (CAMs)
- G-Protein-Coupled Receptors (GPCRs)
- Nuclear Receptor Superfamily
- Pattern Recognition Receptors
- Notch family
- Siglec
- Leukocyte Immunoglobin-like Receptors
- Killer-Cell Immunoglobulin-like Receptors
- Cytokine Receptors
Enzymes & Regulators
- Oxidoreductases (EC 1)
- Transferases (EC 2)
- Hydrolases (EC 3)
- Lyases (EC 4)
- Isomerases (EC 5)
- Ligases (EC 6)
- Translocases (EC 7)
- Matrix Metalloproteinases
- ADAMs/ADAMTSs
- Cathepsin
- Carboxypeptidase
- Angiotensin-converting Enzymes
- Caspase
- Carbonic Anhydrase
- Serine/Threonine Kinase Proteins
- Protein Tyrosine Kinases
- Phosphatase
- Topoisomerase
- Protease Inhibitors
- Protein Kinase Inhibitor Peptide (PKI)
- Cyclin-Dependent Kinase Inhibitor Proteins
- Cystatin Family